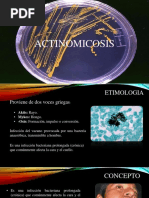

UNIVERSIDAD DE EL SALVADOR FACULTAD DE CIENCIAS AGRONOMICAS DEPARTAMENTO DE MEDICINA VETERINARIA
ACTINOMICOSIS Enfermedades Parasitarias.
PROFESOR: Dr. MV Orlando Silva
ALUMNO: Miguel ngel Pea Molina
CIUDAD UNIVERSITARIA, 15 de Junio de 2009.
�INDICE
CONTENIDO
PAG. 3
1. INTRODUCCIN. 2. OBJETIVOS...................................................................... 4
3. ACTINOMICOSIS........... 5 3.1 DEFINICION 5 3.2 ETIOLOGIA.. 5 3.3 DISTRIBUCION. 6 3.4 PATOGENESIS. 6 3.5 SIGNOS Y SNTOMAS 7 3.6LESIONES 7 3.7 DIAGNOSTICO 8 3.8 TRATAMIENTO 8 3.9 PROFILAXIS. 8 3.10 ASPECTOS EPIDEMIOLOGICOS 9 4. CONCLUSIONES......................................................................................... 10 5. REFERENCIAS BIBLIOGRAFICAS.................................................................. 11 .
�INTRODUCCION. La actinomicosis es una enfermedad crnica de origen bacteriano, del gnero Actinomyces. Se caracteriza por la presencia de abscesos indurados y voluminosos, adems de la existencia de mltiples fstulas de drenaje que pueden localizarse en distintos rganos y tejidos, de preferencia en la regin crvico-facial. Puede presentarse como enfermedad oportunista en pacientes inmunocomprometidos, En 1878 se describe por primera vez en humanos lesiones anlogas a la actinomicosis bovina y se constata su crecimiento anaerobio. Su incidencia ha ido disminuyendo considerablemente debido a la utilizacin masiva de antimicrobianos, siendo en la actualidad una enfermedad relativamente rara. La actinomicosis supone un reto diagnstico, ya que tiene una presentacin clnica anodina y muy inespecfica y simula otras enfermedades. Por otra parte responde muy bien a los antibiticos, de ah la importancia de pensar en esta entidad y realizar un diagnstico precoz.
�OBJETIVOS.
GENERAL. Conocer los procesos patolgicos causados por las diferentes especies del gnero Actinomyces y su incidencia en las diferentes especies.
ESPECIFICOS.
Identificar el agente causal de la actinomicosis en los diferentes animales domsticos.
Diferenciar las lesiones producidas por bacterias del gnero Actinomyces y las producidas por hongos.
Conocer las lesiones producidas por los actinomicetos e identificar los grnulos de azufre.
�ACTINOMICOSIS DEFINICIN. La actinomicosis es una infeccin supurativa crnica que se caracteriza por la produccin de "grnulos de azufre" a partir de fstulas externas. El trmino actinomiceto es tomado del griego y significa hongo de rayos. La actinomicosis es debida a una bacteria anaerbica grampositiva. En la actualidad se reconoce 13 especies, todas son habitantes normales de las mucosas. La actinomicosis es determinada por bacterias semejantes a hongos y depende de varios miembros del orden actinomicetales, entre los que destaca el Actinomyces israelii. Al contrario de la nocardiosis o el actinomicetoma la actinomicosis es una enfermedad endgena. Los microorganismos causales existen como comensales; en la mucosa de la cavidad bucal, las criptas amigdalianas y las vas genitales femeninas. Cuando la barrera mucosa se altera o se rompe, los microorganismos pueden entrar. La infeccin y la enfermedad, a menudo, se relacionan con procedimientos odontolgicos, traumatismos, intervenciones quirrgicas o neumona por aspiracin. Los actinomices son bacterias superiores muy cercanas en muchas caractersticas a los hongos. Son Gram positivos, no esporogenos, no acidorresistentes, de anaerobios a microaerofilicos y se encuentran en la flora normal de la boca, intestino y el tracto genital femenino. ETIOLOGA. Actinomyces israelii: es el principal agente etiolgico en el hombre, pertenece a la flora normal de la boca y la vagina. Con lesiones granulomatosas crnicas. Pero tambin se ha aislado en lesiones piogranulomatosas de los cerdos y el ganado vacuno. Actinomyces bovis: es el agente etiolgico de la quijada aterronada de ganado vacuno, tambin se ha aislado en abscesos nodulares en los pulmones de ganado vacuno y en infrecuentes infecciones en ovejas, cerdos, perros y otros mamferos incluyendo la atrofia crnica fistulosa y el desmochado maligno del caballo. Otras especies A. naeslundi: se ha aislado en infecciones supurativas de varias especies animales, mas frecuentemente en fetos porcinos abortados. A viscosus: causa neumona crnica, piotorax y abscesos subcutneos localizados en los perros. Si este patgeno coloniza
�el SNC puede desencadenar signos parecidos a los del moquillo e incluso hidrocefalia. A. bordeovulneris: produce abscesos localizados e infecciones sistmicas tales como pleuritis, peritonitis, abscesos viscerales y artritis sptica en perros. A. pyogenes: (Corynebacterium): es el agente etiolgico de numerosas enfermedades, principalmente en ganado vacuno pero tambin en ovejas, cabras y cerdos entre estas incluyen mastitis supurativa aguda y crnica, neumona supurativa (habitualmente como secuela de la enfermedad respiratoria bovina causada por Pasteurella multocida y P. haemoltica), septicemia, endocarditis vegetante, endometritis, artritis sptica, infecciones de heridas como las del ombligo, vesiculitis seminal (toros y jabales) y mastitis de verano. A. suis: causa mastitis piogranulomatosa en los cerdos, esta se caracteriza por la presencia de pequeos abscesos en las ubres que contienen pus de color amarillento adherente y viscoso, rodeado de una amplia zona de tejido conectivo denso. En casos mas crnicos los abscesos de localizacin profunda pueden drenar a travs de fistulas, cuyos orificios de salida pueden tener la apariencia de ulcera granulada. Tambin pueden desarrollar ndulos granulomatosos o abscesos bajo la piel del abdomen. Ocasionalmente las infecciones piogranulomatosas se pueden desarrollar en los pulmones, el bazo, riones y otros rganos. En algunos informes se seala el aislamiento de A. israelii en los animales y A. bovis en el hombre. DISTRIBUCION. Mundial aunque la frecuencia de la enfermedad tiene grandes variaciones regionales y las diferentes prcticas de manejo del ganado vacuno influyen en la incidencia. Generalmente la enfermedad se presenta en forma de casos espordicos. En algunas zonas cenagosas de los Estados Unidos de Amrica y la antigua unin sovitica se han producido brotes pequeos. PATOGENESIS. En la patogenia de la actinomicosis, la disrupcin de las barreras anatmicas es el evento inicial que permite el acceso de la flora comensal oral, intestinal o genital hacia los tejidos vecinos y hacia el torrente sanguneo. Una disrupcin oculta de la mucosa intestinal o genital puede haber proporcionado la puerta de entrada al Actinomyces y su extensin a tejidos contiguos en pacientes con enfermedad digestiva crnica, ciruga abdominal previa, traumatismo local y uso prolongado de DIU.
�A. bovis es el agente principal de la actinomicosis en los bovinos y ocasionalmente en otras especies animales. En los bovinos se asienta principalmente en los maxilares, donde forma tejido granulomatoso con reas necrticas que se transforman en abscesos. Estos se abren por conductos fistulosos y descargan un pus viscoso e inodoro de color amarillo. El pus contiene pequeos grnulos amarillos llamados grnulos de azufre que aparecen como rosetas en la observacin microscpica. En algunos casos la masticacin resulta muy dificultosa el animal se abstiene de consumir alimento y pierde peso. La osteomielitis actinomictica en el esqueleto axial se puede producir mediante la diseminacin del agente por va hematgena desde un foco contagioso y es frecuente en animales viejos septicmicos. Tambin, se puede presentar por inoculacin directa en los casos de trauma o ciruga ortopdica de fracturas abiertas situacin en la que el tipo de patgenos mas frecuentemente implicados son los estafilococos y estreptococos Las infecciones y los procesos patolgicos se producen por traumas tisulares, lesiones e irritaciones prolongadas. Los agentes que producen actinomicosis no se han encontrado en el medio ambiente. Se cree que los agentes penetran por los tejidos de la boca a travs de las lesiones causadas por alimentos u objetos extraos o a travs de los defectos dentarios. Desde la cavidad oral la bacteria puede ser aspirada o ingerida a los bronquios. SIGNOS Y SNTOMAS. Aparicin de masa abdominal Dolor abdominal Sndrome constitucional Sntomas urinarios Masa abdominal palpable Dolor a la palpacin abdominal Fiebre Desnutricin
LESIONES. La infeccin ocurre generalmente en inmunocompetentes y tpicamente tiene como puerta de entrada una disrupcin de la mucosa del tracto gastrointestinal, pero la aspiracin de secreciones de la orofaringe o tracto gastrointestinal hacia el tracto respiratorio y la presencia de dispositivo intrauterino, son tambin factores de riesgo importantes. Tanto en cara y cuello, sitios ms frecuentes de infeccin, como en otros sitios afectados, la enfermedad puede manifestarse
7
�como un absceso pigeno doloroso o como un cuadro indolente que evoluciona en forma crnica, formando masas induradas indoloras a menudo acompaadas de tractos fistulosos que descargan grnulos actinomicticos. DIAGNOSTICO. El diagnstico de actinomicosis se hace ms certeramente aislando especies de Actinomyces en medios de cultivo para anaerobios, pero la demostracin de grnulos actinomicticos (grnulos de azufre) en exudados y cortes histolgicos sugieren fuertemente el diagnstico. Es infrecuente su visualizacin con tinciones de uso habitual, pero esta se facilita al usar tinciones especiales como la de Grocott-Gomori y el cido p-amino saliclico, Tincin de Gram y cultivo bacteriolgico utilizando la tcnica de anaerobios estrictos. El cuadro clnico se puede confundir con otras infecciones, tales como: Actinobacilosis, nocardiosis y estafilococosis como tambin con neoplasmas y tuberculosis. Se pueden realizar pruebas que identifican los filamentos que contiene los grnulos pustulares, lavando el granulo con agua destilada y colocndolo sobre un portaobjeto y luego presionndolo con un cubre objeto y realizando la tincin con HE o tincin de Gram. En mujeres que utilizan dispositivos intrauterinos se ha demostrado la eficacia de la Inmunofluorescencia directa. No existen alteraciones en la biometra hemtica ni qumica sangunea que sean sugestivos para confirmar el diagnostico. TRATAMIENTO. El tratamiento de eleccin para todas las formas clnicas de la enfermedad es el uso prolongado de antibiticos, como penicilina, evitando as las recadas y asegurando un pronstico favorable. Tambin es normativa la reseccin del tumor por desbridamiento quirrgico (cuando sea posible) y la antibioterapia. Actinomyces spp. Son susceptibles a los antimicrobianos -lactmicos, como las penicilinas y las cefalosporinas pero son resistentes a las sulfamidas. Para los animales alrgicos a las penicilinas se pueden emplear tetraciclinas y eritromicinas son alternativas razonables PROFILAXIS. La prevencin en el hombre consiste en una buena higiene bucal y en el cuidado despus de extracciones dentales y otras operaciones de la
8
�cavidad oral. En cuanto a actinomicosis animal, hasta ahora no se han podido establecer medidas prcticas para prevenirlas.
ASPECTOS EPIDEMIOLGICOS. Las especies de Actinomyces que atacan al humano y a los animales son diferentes, rara vez se encuentra A. bovis en el hombre y A. israelii en los animales. Por lo que una distincin entre una especie y otra tropieza con grandes dificultades, la infeccin de animales no se transmite al hombre, tampoco hay transmisin de hombre a hombre y de animal a animal. Afectando mayormente a los que estn en un estado de inmunocompromiso.
�CONCLUSIONES.
La identificacin de los diferentes agentes causales de la actinomicosis es uno de los problemas con los que se encuentra un medico, ya que si no dispone de los materiales adecuados le es muy difcil de diagnosticar el agente etiolgico, ya que los sntomas se asemejan a otras enfermedades micticas y bacterianas, es necesario mantener una limpieza bucal adecuada de la cavidad bucal, ya que esta podra ser una fuente de infeccin para el propio individuo.
10
�REFERENCIAS BIBLIOGRAFICAS
Castro Mendoza, Isidro. 1996. EXAMEN GENERAL DE CALIDAD PROFESIONAL. Para Medicina Veterinaria y Zootecnia. Material de estudio: rea Caninos y Felinos. Volumen 1. Consejo nacional de educacin de la Medicina Veterinaria y Zootecnia, A.C. Sistema Universidad Abierta (UNAM). p. 79. Aiello, S.E; Mays, A. 2000. El manual Merck de veterinaria. 5a edicin en espaol. Editorial Ocano. Barcelona, Espaa. p.478-480 Lapage, Geoffrey. Parasitologa Veterinaria. EDITORIAL CONTINENTAL, S.A. Mxico D.F COMPAA
Borchert, Alfred. Parasitologa Veterinaria. 1 Edicin. Editorial Acribia. Zaragoza, Espaa. http://74.125.45.132/search?q=cache:PiN0_NqAZsEJ:www.udec. cl/~ofem/remedica/VOL6N302/actinomic.htm+actinomicosi a&cd=2&hl=es&ct=clnk&gl=sv http://bvs.panaftosa.org.br/textoc/Acha_v1_actinomicosis.pdf.
11